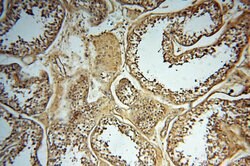
SYK Rabbit anti-Human, Mouse, Rat, Polyclonal, Proteintech 150 &mu;L; Unconjugated:Antibodies,

missing translation for 'onlineSavingsMsg'
Learn More
Learn More
SYK Rabbit anti-Human, Mouse, Rat, Polyclonal, Proteintech
Rabbit Polyclonal Antibody
Brand: Proteintech 14858-1-AP-150UL
This item is not returnable.
View return policy
Description
This gene encodes a member of the family of non-receptor type Tyr protein kinases. This protein is widely expressed in hematopoietic cells and is involved in coupling activated immunoreceptors to downstream signaling events that mediate diverse cellular responses, including proliferation, differentiation, and phagocytosis. It is thought to be a modulator of epithelial cell growth and a potential tumor suppressor in human breast carcinomas. Alternatively spliced transcript variants encoding different isoforms have been found for this gene.Specifications
| SYK | |
| Polyclonal | |
| Unconjugated | |
| SYK | |
| spleen tyrosine kinase, SYK, Tyrosine protein kinase SYK | |
| Rabbit | |
| Antigen Affinity Chromatography | |
| RUO | |
| 20963, 25155, 6850 | |
| -20°C | |
| Liquid |
| Immunohistochemistry (Paraffin) | |
| 0.21 mg/mL | |
| PBS with 50% glycerol and 0.02% sodium azide; pH 7.3 | |
| P43405, P48025, Q64725 | |
| SYK | |
| SYK Fusion Protein Ag6657 | |
| 150 μL | |
| Primary | |
| Human, Mouse, Rat | |
| Antibody | |
| IgG |
Product Content Correction
Your input is important to us. Please complete this form to provide feedback related to the content on this product.
Product Title
Spot an opportunity for improvement?Share a Content Correction